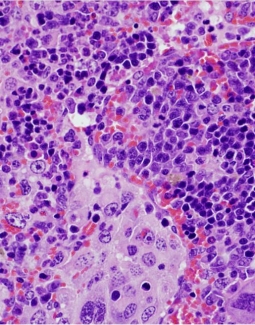

Descubren que una alteración que afecta al gen VAV1 es clave en el desarrollo de estos tumores y desempeña funciones pro-tumorales distintas según el órgano en el que surge
Un equipo de investigación liderado por el Consejo Superior de Investigaciones Científicas (CSIC) ha identificado que una alteración genética que afecta al gen VAV1 desempeña un importante papel en tumores derivados de los linfocitos T (linfomas) y el cáncer de pulmón, dos tipos de cánceres que se caracterizan por tener tasas de supervivencia muy bajas.
UNICEF/Aleksey Filippov Los psicólogos están apoyando a los adolescentes vulnerables mientras el bloqueo de COVID-19 hace mella en su salud mental.
Las tasas de ansiedad, depresión y estrés postraumático se han disparado en todo el continente, según un estudio reciente de la Organización Panamericana de la Salud. Además, los índices de violencia en la región triplican la media mundial antes de la pandemia. La violencia doméstica contra mujeres y niños se ha recrudecido.
Investigadores del CSIC han analizado el papel de una proteína relacionada con estados tumorales avanzados en el proceso de transición de células madre a células diferenciadas
-
Oct 31, 19:17 pm
Un estudio del CSIC revela una mutación genética clave en la aparición de linfomas y el cáncer de pulmón
-
Oct 27, 16:15 pm
El efecto devastador del COVID-19 en la salud mental
-
Oct 13, 10:28 am
Identificado un nuevo mecanismo de diferenciación celular relacionado con la metástasis de cáncer de pulmón